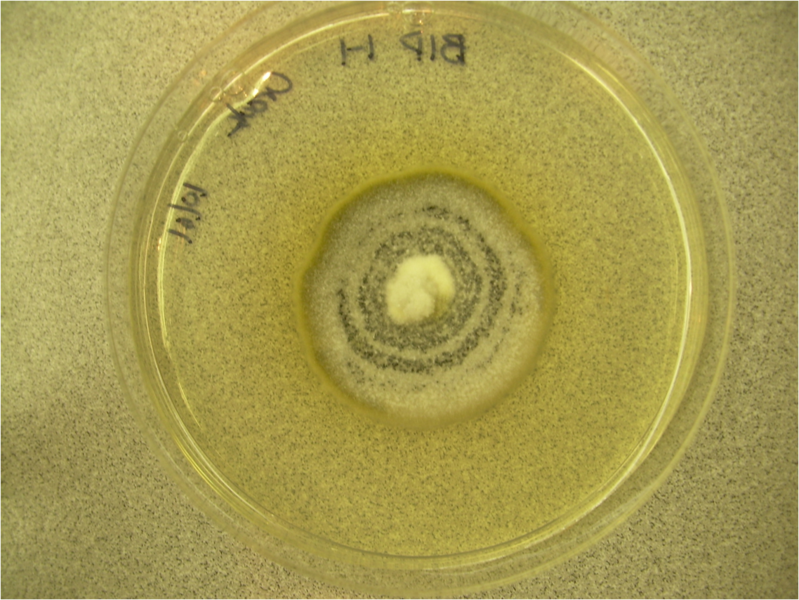

File:Diplodia plate.png
From Wikimedia Commons, the free media repository
Size of this preview: 799 × 600 pixels. Other resolutions: 320 × 240 pixels | 640 × 480 pixels | 1,024 × 768 pixels.
Original file (1,138 × 854 pixels, file size: 2.41 MB, MIME type: image/png)
Summary[edit]
Description |
English: Diplodia hederae growing on a potato dextrose agar plate. Identified using Barnett, H. L. & Hunter, B. B. (1998) Illustrated Genera of Imperfect Fungi. APS Press: St. Paul, MN; pp. 180–1 ISBN 0-89054-192-2.
|
Date | |
Source | Own work |
Author | Ninjatacoshell |
![]() |
This is a retouched picture, which means that it has been digitally altered from its original version. Modifications: this photograph was saved as an image in a MS Word document and then recovered as a .png.
|
Licensing[edit]
I, the copyright holder of this work, hereby publish it under the following licenses:
You may select the license of your choice.
|
File history
Click on a date/time to view the file as it appeared at that time.
Date/Time | Thumbnail | Dimensions | User | Comment | |
---|---|---|---|---|---|
current | 16:20, 12 May 2009 | ![]() | 1,138 × 854 (2.41 MB) | Ninjatacoshell (talk | contribs) | {{Information |Description={{en|1=''Diplodia'' growing on a potato dextrose agar plate. Identified using '''Barnett, H. L. & Hunter, B. B.''' (1998) ''Illustrated Genera of Imperfect Fungi.'' APS Press: St. Paul, MN; pp. |
- You cannot overwrite this file.
File usage on Commons
The following page links to this file: